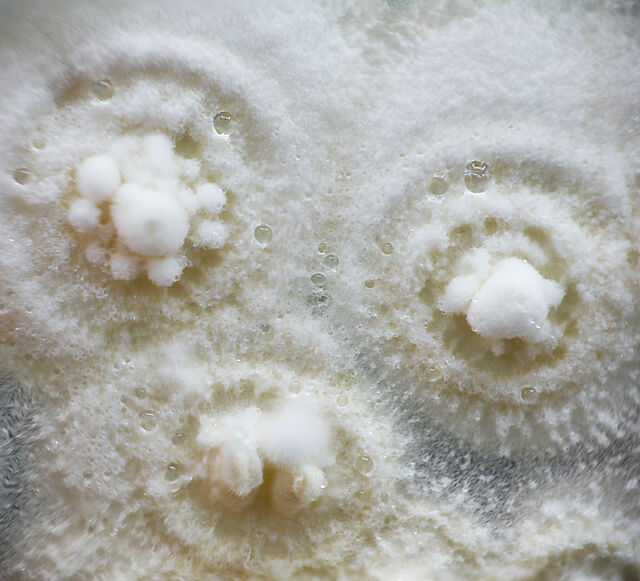

What are beneficial microorganisms?
Beneficial microorganisms, also known as beneficial microbes, are microorganisms that provide positive effects to their environment, including various biological systems and organisms. These microorganisms play a crucial role in biological pest control by effectively infecting and controlling harmful pests.
Beneficial microorganisms for pest control include fungi, bacteria and viruses that naturally occur in environments such as soil, water, and air. These microorganisms are harnessed for pest control through applications like biopesticides, where they are introduced to target pests, providing an eco-friendly alternative to chemical pesticides.
Well-known examples of beneficial microbes are the fungi Akanthomyces muscarius, Beauveria bassiana, Metarhizium anisopliae and Isaria fumosoroseus and the bacterium Bacillus thuringiensis.
Beneficial microorganisms for pest control
How it works
- Infection and colonization: Beneficial microorganisms start by infecting their insect hosts. The fungi produce spores that attach to the insect's cuticle (outer covering). Once attached, the spores germinate, penetrate the cuticle, and colonize the insect's body.
- Internal damage: Once inside the insect, the fungus proliferates, causing internal damage. This can lead to the insect's death.
- Spore production: As the insect succumbs to the fungal infection, the fungus continues to grow. Eventually, it produces more spores, which can be released into the environment to infect other pests.
Advantages of microorganisms in agriculture
No harmful residue
Unlike chemical pesticides, beneficial microorganisms pose minimal risk to the environment. They break down naturally, leaving no harmful residues.
Precision pest control
Beneficial microorganisms are specific to their target pests, like aphids, whitefly and thrips, minimizing harm to beneficial insects, and other non-target organisms.
Reduced pesticide dependency
Incorporating beneficial microorganisms into pest management strategies reduces the need for chemical pesticides, contributing to more sustainable and eco-friendly agriculture.
Beneficial microorganism products
Koppert offers a range of beneficial microorganisms products that have become instrumental in pest management for sustainable agriculture. Leveraging nature's own defenses, Koppert uses the power of entomopathogenic fungi, such as Akanthomyces muscarius (Mycotal), Beauveria bassiana (Boveril), Metarhizium anisopliae (Metarril) and Isaria fumosoroseus (Isarid), to provide effective solutions for pest control. These beneficial microorganisms products, carefully developed and backed by years of research, are designed to target specific pests, delivering precision pest control and efficacy. Availability of these products depends on country-specific regulations.
Beneficial microorganisms can be applied through various spraying methods. The specific application method depends on the target pests and the crop type.
Succes stories
Frequently Asked Questions
-
What are beneficial microorganisms, and how do they contribute to pest control in agriculture?
Beneficial microorganisms, particularly entomopathogenic fungi as Lecanicillium muscarium (Mycotal), Beauveria bassiana (Boveril), Metarhizium anisopliae (Metarril) and Isaria fumosoroseus (Isarid), are naturally occurring organisms that infect and kill insects. In agriculture, they serve as powerful allies in pest control by specifically targeting and reducing the populations of harmful pests.
-
Are beneficial microorganisms safe for crops and the environment?
Yes, beneficial microorganisms are environmentally friendly and pose minimal risk to crops and non-target organisms. They are a natural alternative to chemical pesticides, leaving no harmful residues and contributing to sustainable agricultural practices.
-
How do I apply beneficial microorganisms to my crops?
Beneficial microorganisms can be applied through various spraying methods. The specific application method depends on the target pests and the crop type. Koppert provides comprehensive guidance on the appropriate application techniques for their range of beneficial microorganism products.
-
Can beneficial microorganisms be used in organic farming?
Yes, beneficial microorganisms are suitable for organic farming. They align with the principles of organic agriculture by providing a natural and biological solution to pest problems, without the use of synthetic chemicals.
-
Do beneficial microorganisms harm beneficial insects or other non-target species?
No, beneficial microorganisms are specific to their target pests and typically do not harm beneficial insects or other non-target species. This precision targeting makes them a valuable component of integrated pest management (IPM) strategies.
-
When are the effects of beneficial microorganisms visible?
In many cases, noticeable effects on pest populations can be observed within a few days to weeks after application.
-
Can beneficial microorganisms be used preventively, or are they only effective once pests are present?
Beneficial microorganisms are not used preventively. Microorganisms are effective in addressing existing pest infestations, contributing to a more resilient and sustainable farming system.